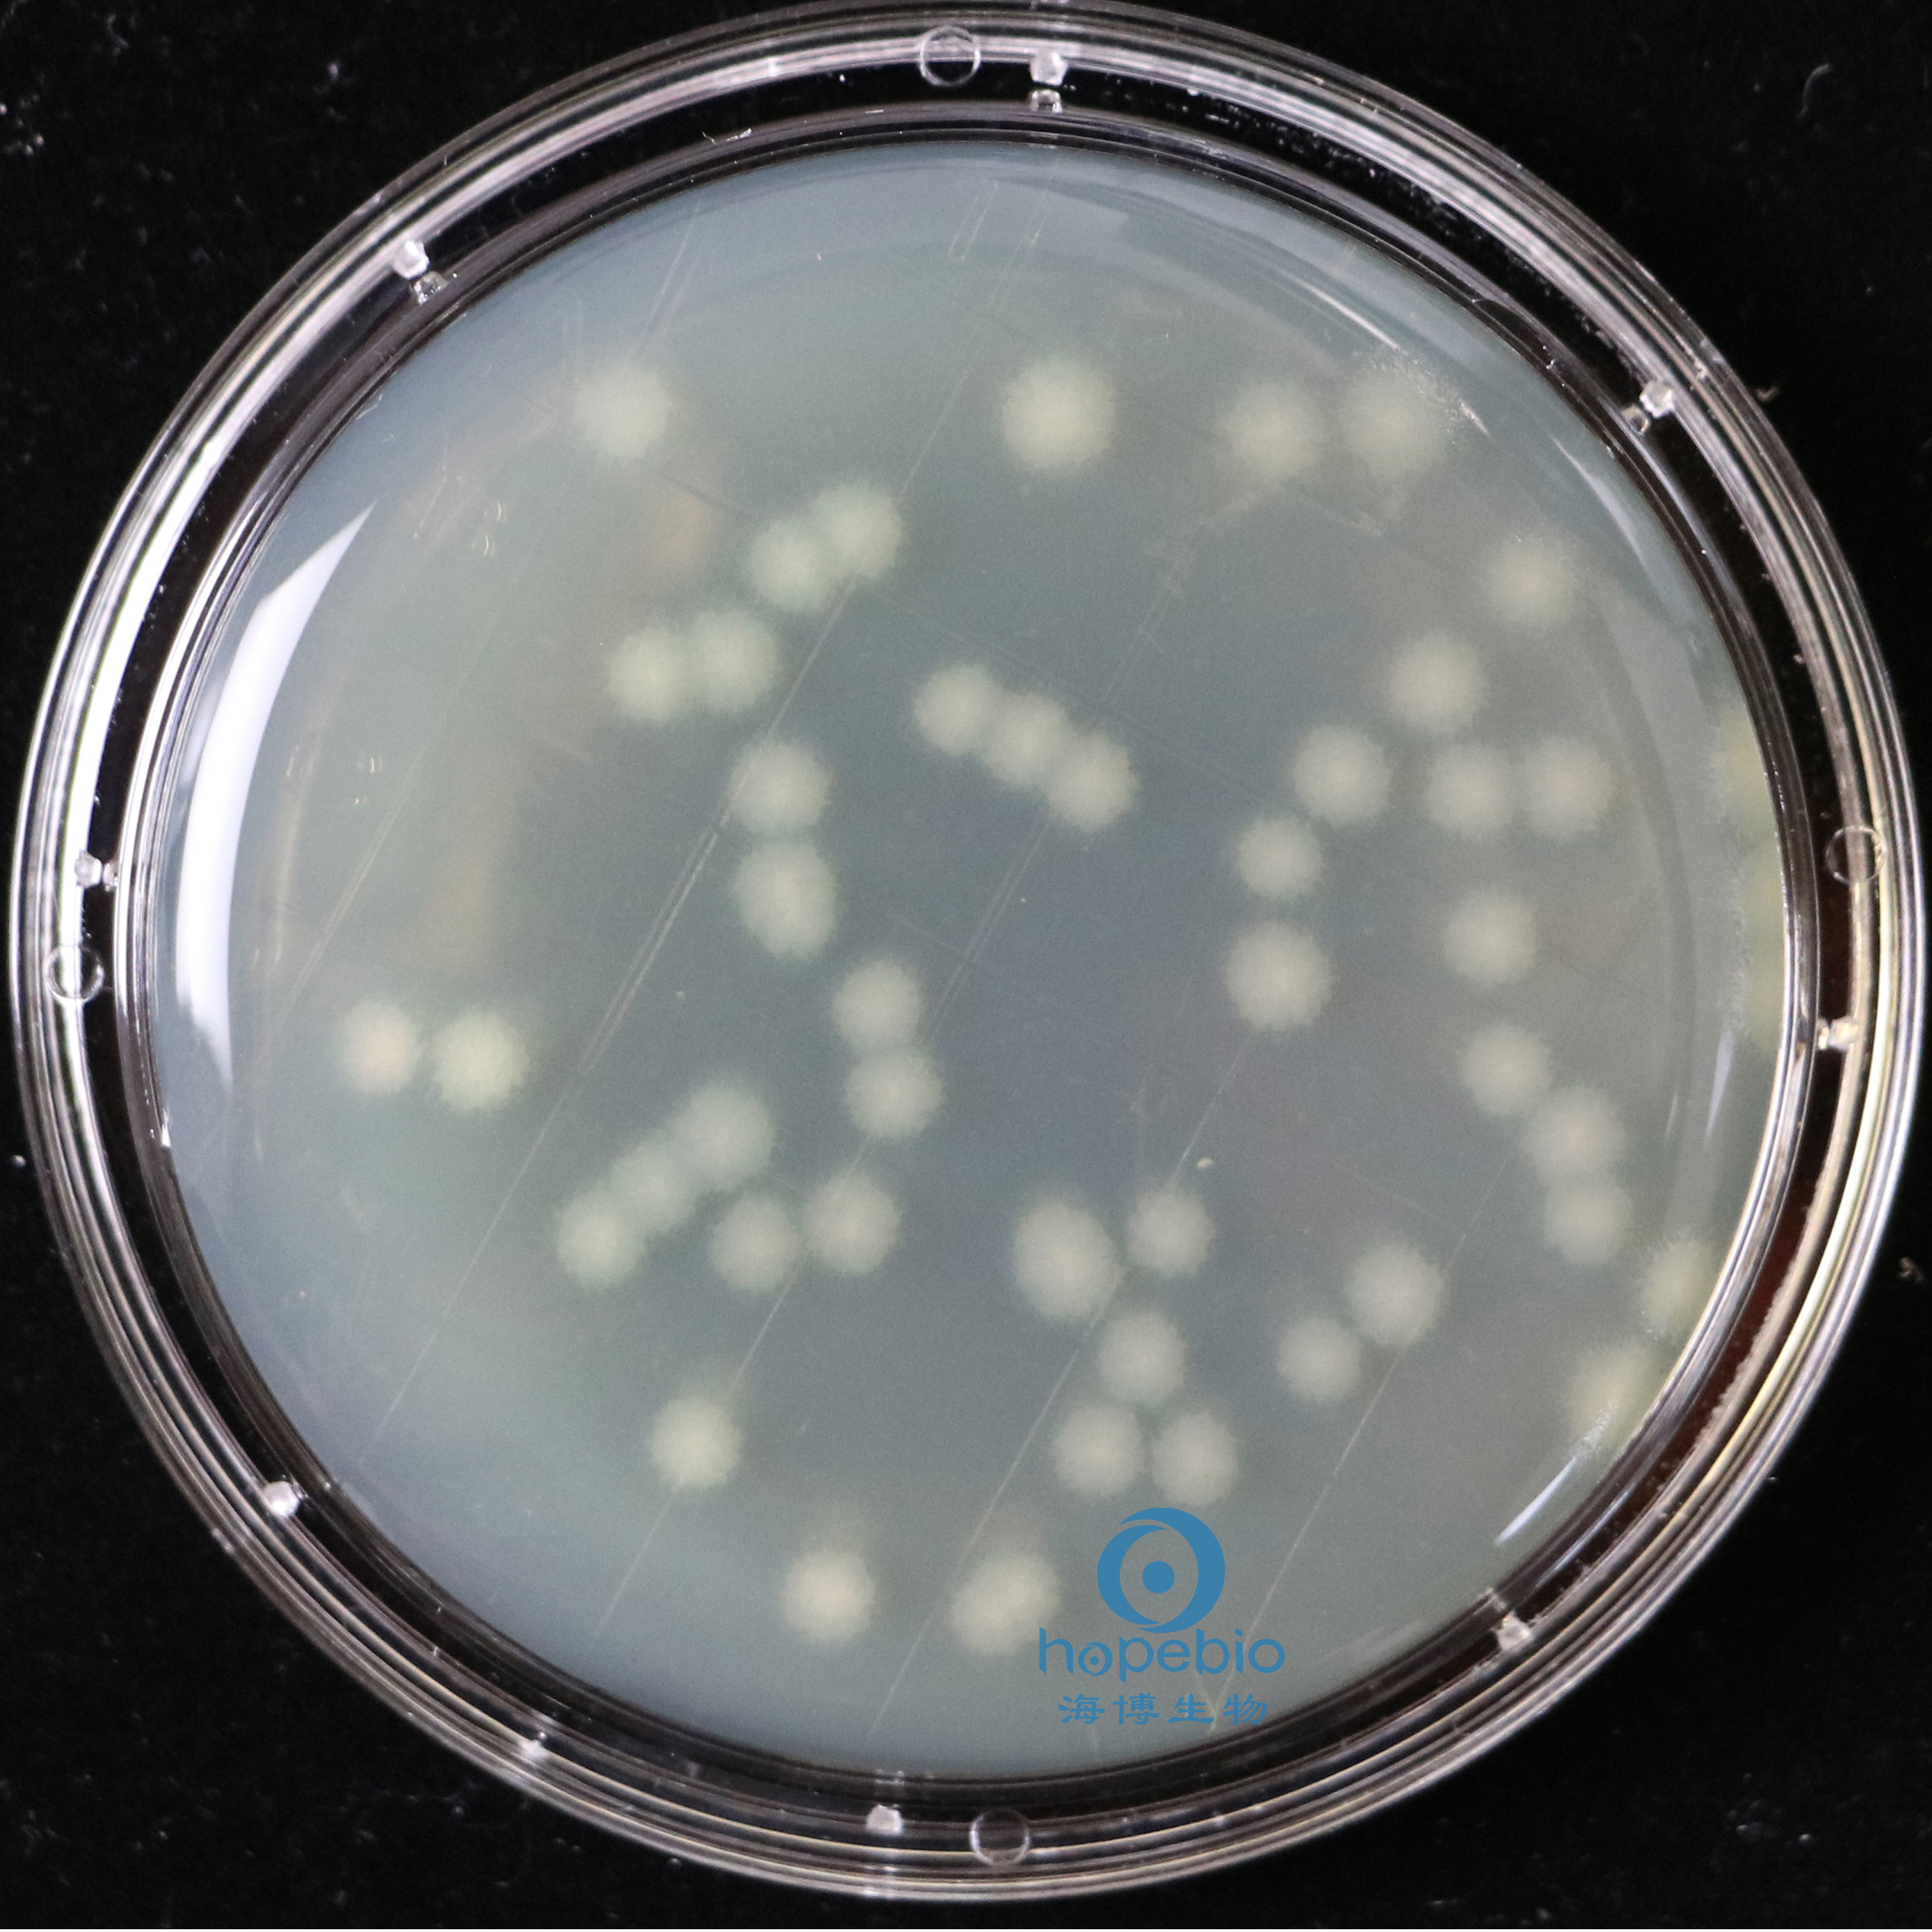
产品细节图片8

相关产品推荐更多 >
万千商家帮你免费找货
0 人在求购买到急需产品
- 详细信息
- 询价记录
- 文献和实验
- 技术资料
- 保存条件:
/
- 保质期:
6个月
- 英文名:
RODAC
- 库存:
999
- 供应商:
青岛海博生物
- 规格:
10个/包



Replicate Organism Detection and Counting,是一种检测物体表面微生物污染的技术,方法是用琼脂培养基的凸起面直接接触预检测场所的表面。这种方法特别适用于在平滑密实的表面采样,在不规则、破裂或有裂纹的表面都不宜使用这种方法。
不同细菌在TSA表面接触皿生长特征:
![]() |
![]() |
|||||
| jin黄色葡萄球菌 有黄色色素 |
大肠杆菌 无色透明大菌落 |
|||||
![]() |
![]() |
|||||
| 伤han沙门氏菌 无色大菌落 |
枯草芽孢杆菌 白色不规则菌落 |
|||||
![]() |
![]() |
|||||
| 铜绿假单胞菌 有绿色色素 |
白色念珠菌 白色菌落 |
![]() |
||||
| 黑曲霉 有黑色孢子 |
接种以下质控菌株,放置30-35℃需氧培养18-24小时。
注:回收率计算时,用TSA琼脂做对照培养基。

风险提示:丁香通仅作为第三方平台,为商家信息发布提供平台空间。用户咨询产品时请注意保护个人信息及财产安全,合理判断,谨慎选购商品,商家和用户对交易行为负责。对于医疗器械类产品,请先查证核实企业经营资质和医疗器械产品注册证情况。
- 作者
- 内容
- 询问日期
文献和实验/qttn3TNtupuJ3Dhju1Xb58peVqTZs4bbIIMtMDRbgld0db3jav2WKjxo2UBrliTz7zjA0dOVZ1HwcF9zpBhhsSCA0yJiKJiTJXY4gIvHkIxFevNw/rWFJEICIQEYgI7O8IMHGuv1fkrmm/fuIRO2veXJs18+jEDrgsTw7y7PDe977X3nHpu2WPbLZi9Vo77+0X2WGHz7JrrrnGerZssnPnzbP588+22bPn2Nz55/sEue9+97t2xRWXuwb
培养皿培养。24h后换成DF12+N2的无血清培养液,此后每三天半量换液1次。 瓶底星形胶质细胞的继续培养 25cm2培养瓶内的星形胶质细胞用D-Hanks液洗2次后常规传代,以1.5×105/cm2种入预先用100μg/L多聚赖氨酸包被好的35mm培养皿培养。培养液为GM,每三天半量换液1次。 动脉粥样硬化患者VSMC的提取 实验材料:眼科剪刀1把 眼科镊子2把 1×PBS约200ml M199培养液 离心机 5ml小皿 10ml大皿 实验步骤: 1.在超净台内用10ml的离心
胨) 0.1g Glucose (葡萄糖) 1g Tap water (自来水) 1000ml [Note]:Boil the mixture in autoclave at 121℃ for 1 hr. distribute the medium into 18ⅹ18 mm tubes , each contains 10 ml of the liquid , then autoclave at 121℃ for 1 hr . again (15磅蒸煮1小时,分装入18ⅹ18毫米试管,每管深度达6厘米
技术资料暂无技术资料 索取技术资料